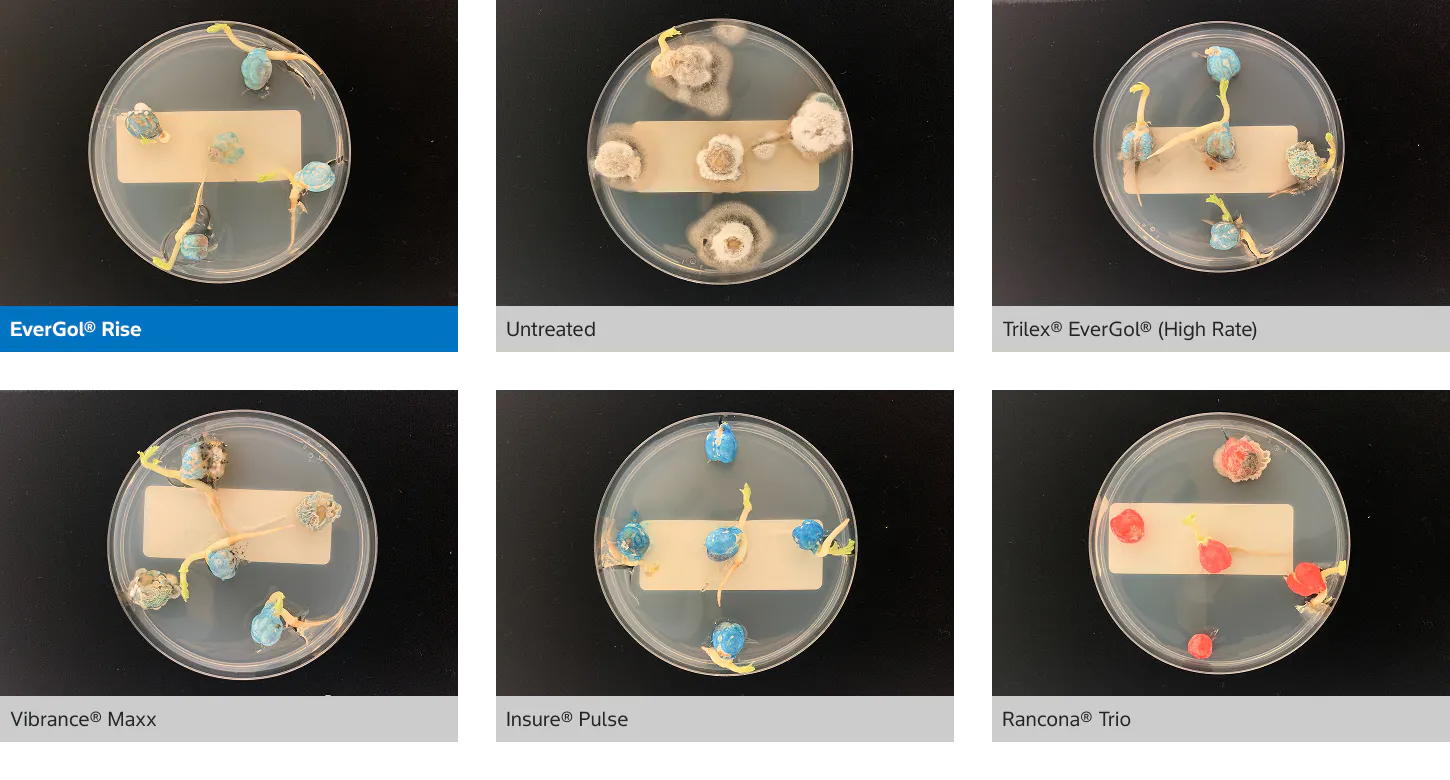
6 different comparison images of soil-borne pathogens with different treatments. Image 1 EverGol® Rise: Petri dish containing soybean seeds with minimal mold growth and small yellow sprouts. The dish appears clean compared to others. Image 2 Untreated: Petri dish showing untreated soybean seeds heavily covered in white and gray mold colonies, with no healthy sprouts visible. Image 3 Trilex® EverGol® (High Rate): Petri dish with soybean seeds showing limited mold and several elongated yellow sprouts, indicating stronger germination. Image 4 Vibrance® Maxx: Petri dish featuring soybean seeds with moderate mold patches and several yellow sprouts of varying lengths. Image 5 Insure® Pulse: Petri dish with soybean seeds showing minimal mold and multiple healthy yellow sprouts emerging from the seeds. Image 6 Rancona® Trio: Petri dish containing red‑coated soybean seeds with noticeable mold growth on several seeds and a few emerging yellow sprouts.

Get to the field faster with new EverGol Rise.
It’s go time and you’ve never been more ready. Stay ahead of seed- and soil-borne pathogens, like Ascochyta and Fusarium, with EverGol® Rise pulse seed treatment. Simple to use, easy to handle, tough on disease. It’s time to go full-throttle this spring.

EverGol Rise in action
When seedlings are most susceptible, EverGol Rise strengthens the establishment and emergence of your pulses, boosting crop competitiveness, which can aid weed control and optimize fungicide staging throughout the season.
The added protection of EverGol Rise helps your pulses fight off disease to maximize yield potential.

Source: Bayer Market Development trails, 2024-2025. N = 7
When disease pressures your pulses, yield loss can be substantial. We put EverGol Rise to the test to show the difference it can make on your bottom line—because your investment in protection should pay off.

Source: Bayer Crop Science lentil trial, Saskatoon, SK, 2025. Lentils inoculated with Fusarium.
The EverGol Edge
The disease-fighting quality, consistency, and convenience of EverGol Rise helps protect pulses from early-season, seed-borne pathogens—giving a clean start and stronger, more uniform stands before soil-borne pressures arrive.
Source: Bayer SeedGrowth Lab, Saskatoon, 2021. Chickpeas inoculated with Ascochyta.
Stronger plant stand establishment

Source: Bayer Field Solutions Trials, 2021 & 2023, combined data, 16-24 days after emergence. Pulse crops inoculated with Rhizoctonia and Fusarium: chickpeas, lentils and peas.
Evergol Rise combines four active ingredients, each working together, to provide superior disease control of both seed-borne pathogens like Ascochyta spp., and soil-borne threats like, Fusarium spp. and Rhizoctonia solani, promoting healthier, more resilient crops. With the all-in-one, simple to use formulation of penflufen, trifloxystrobin, metalaxyl and prothioconozole, you’ll be giving your pulses a better head start, while spending less time doing it.



